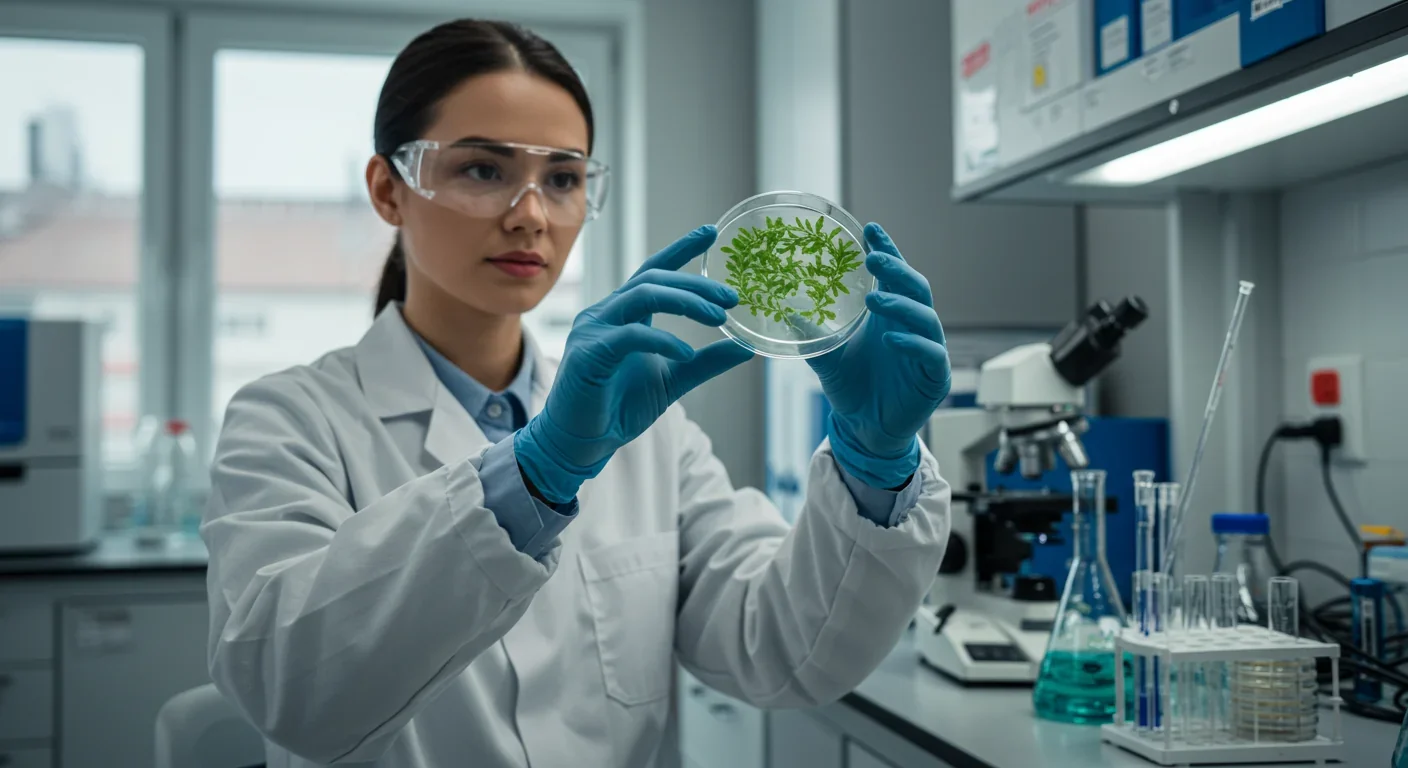

Bombardier Beetle Chemical Defense: Nature's Micro Engine

TL;DR: Resurrection plants survive 99% water loss by entering a death-like state and reviving within hours when water returns—a 450-million-year-old survival trick that scientists are now engineering into crops to combat global drought and water scarcity. Recent breakthroughs include isolating 14 desiccation-tolerance genes, field trials boosting yields in nine crops via molecular priming, and CRISPR edits creating drought-resistant rice and sweet potato. If scaled, these innovations could save 500 billion cubic meters of water annually and stabilize food supplies for 10 billion people, though challenges include yield trade-offs, genetic complexity, and ensuring equitable access for smallholder farmers in the Global South.

By 2050, climate models predict that two-thirds of the world's population will face severe water scarcity. Yet tucked into rocky crevices across Africa, the Americas, and Asia, a small group of plants has already solved this problem—by dying and coming back to life. Resurrection plants can lose 95% of their water, turn brown and brittle as paper, remain dormant for months or even years, and then spring back to vibrant green within hours of touching water. This isn't science fiction. It's evolutionary engineering that took 450 million years to perfect, and scientists believe it holds the key to drought-proofing the crops that feed humanity.
In the Chihuahuan Desert, a peculiar ball of dried vegetation tumbles across the sand. Spanish missionaries in the 1500s called it the "rose of Jericho," marveling at its ability to resurrect after months without rain. Today, botanists know it as Selaginella lepidophylla, and it represents one of nature's most extreme survival adaptations. When water vanishes, this plant doesn't just conserve moisture—it orchestrates a cellular transformation so profound that all measurable metabolic activity ceases. It becomes, by every biological definition, dead. Yet within three to four hours of rehydration, it unfurls green fronds and resumes photosynthesis as if nothing happened.
Only 240 of Earth's 352,000 flowering plant species possess this capability—roughly 0.07% of all angiosperms. Professor Jill Farrant of the University of Cape Town has spent decades studying these botanical marvels. As a child in 1970s South Africa, she watched plants in her yard turn brown during drought, only to regreen within hours after the first rain. That childhood wonder became a career-defining question: What if we could transfer this superpower to wheat, rice, and maize?
The answer could reshape global agriculture. In 2024, the EU's RESIST project sequenced the genomes of Haberlea rhodopensis, Xerophyta elegans, and Xerophyta humilis, identifying 14 candidate genes linked to desiccation tolerance. Field trials using molecular priming—treating crops with bioactive compounds extracted from resurrection plants—increased yields in nine crop species including tomato, raspberry, and onion while reducing sun damage. Meanwhile, a single gene from Xerophyta viscosa inserted into sweet potato allowed transgenic plants to stay green and tall through 12 days of dehydration that wilted conventional varieties. These aren't incremental improvements. They're proof-of-concept demonstrations that resurrection biology can be engineered into staple crops.
Four hundred fifty million years ago, when plants first crawled out of the oceans onto barren rock, they faced an existential crisis: how to survive without constant immersion in water. The earliest land colonizers—bryophytes like mosses and liverworts—solved this problem by evolving desiccation tolerance. These pioneers could dry out completely during droughts and revive when moisture returned, allowing them to establish footholds in environments that would kill any modern crop plant within days.
As vascular plants evolved—developing specialized tissues to transport water and nutrients—most lineages abandoned vegetative desiccation tolerance in favor of deeper roots, waxy cuticles, and stomata that could close to conserve water. These drought-avoidance strategies worked brilliantly for 400 million years, enabling forests, grasslands, and eventually agriculture. But they came with a hidden cost: once water stress exceeded a plant's ability to regulate turgor pressure, cells would collapse irreversibly through a process called cytorrhysis, killing the plant.
A tiny fraction of plant lineages, scattered across mosses, ferns, and flowering plants, retained or re-evolved the ancient desiccation tolerance of their ancestors. Resurrection plants in the genus Craterostigma can reduce leaf water content to 13%—a level that represents cell collapse and death in typical plants—and still recover fully. The resurrection fern Pleopeltis polypodioides festoons oak trees across the American South, curling brown during dry spells and unfurling green within hours of rain. The South African shrub Myrothamnus flabellifolius survives years of drought by folding its leaves into tight bundles and coating its xylem with protective lipids.
What humanity is now learning from these extremophiles echoes an older lesson from agriculture's Green Revolution. In the 1960s, breeding programs increased crop yields by 200-300% through dwarfing genes, improved fertilizer response, and disease resistance. But that revolution was built on abundant water. Norman Borlaug's miracle wheat varieties that saved a billion people from starvation require consistent irrigation. As climate change intensifies droughts and makes rainfall unpredictable, we need a Blue Revolution—crops engineered to thrive with minimal water. Resurrection plants are the blueprint.
When a resurrection plant senses drought, it initiates a molecular cascade that would kill an ordinary plant. Understanding this process requires looking inside the cell during extreme dehydration.
The Sugar-Glass Strategy: As water content drops below 40%, resurrection plants flood their cells with protective sugars—primarily trehalose and sucrose. These molecules aren't just osmoprotectants. At concentrations reaching 10-20% of dry weight, they perform a remarkable trick called vitrification: they form a viscous, glass-like matrix that immobilizes cellular structures. This biological glass replaces the water molecules that normally interact with proteins and membranes, preserving their three-dimensional structure even as the cell desiccates to 3% of its original mass.
Trehalose, a disaccharide composed of two glucose molecules linked by an α,α-1,1-glycosidic bond, is particularly effective because its molecular structure prevents it from participating in the damaging Maillard reactions that occur at low water levels. Studies of Selaginella lepidophylla show trehalose accumulation correlates directly with desiccation tolerance—the sugar acts as a water substitute, forming hydrogen bonds with phospholipid headgroups to prevent membranes from fusing or cracking as they compress during dehydration. In cryopreservation experiments with human embryos, trehalose-based vitrification solutions achieved 52.8% implantation rates versus 43.9% for sucrose solutions, demonstrating that trehalose's higher glass transition temperature (110-120°C) creates more stable protection.
LEA Proteins: Molecular Bodyguards: Late Embryogenesis Abundant (LEA) proteins are the Swiss Army knives of desiccation tolerance. First discovered in plant seeds—which routinely survive desiccation during maturation—LEA proteins are intrinsically disordered proteins that lack a fixed three-dimensional structure. This disorder is their superpower. As water disappears, LEA proteins bind to other cellular proteins and to membranes, preventing aggregation and maintaining functional conformations.
These proteins are evolutionarily ancient and remarkably conserved. They appear not only in resurrection plants but also in the bacterium Deinococcus radiodurans (which survives extreme radiation), nematode worms, brine shrimp, and tardigrades—all organisms capable of anhydrobiosis. Research shows LEA proteins are particularly protective of mitochondrial membranes, the cellular powerhouses most vulnerable to dehydration damage. In resurrection plants, LEA protein synthesis ramps up as drought intensifies, with some species maintaining constitutively high levels even when fully hydrated, providing always-on protection.
Membrane Remodeling: Cell membranes are lipid bilayers whose fluidity depends on temperature and hydration. During desiccation, membranes risk transitioning from a fluid to a rigid gel phase, which can cause them to crack or fuse. Resurrection plants counter this through membrane remodeling—adjusting the ratio of saturated to unsaturated fatty acids and altering headgroup composition.
Studies of Boea hygroscopica, a resurrection plant in the Gesneriaceae family, reveal that thylakoid membranes undergo dramatic lipid changes during dehydration. The plant increases levels of phosphatidylcholine and cardiolipin while reducing others, a process called homeoviscous adaptation. These changes maintain optimal membrane fluidity despite water loss. Additionally, resurrection plants accumulate betaines—small organic compounds that stabilize protein structure and membrane integrity. Selaginella lepidophylla produces both trehalose and betaines, suggesting multiple compatible solutes work synergistically.
Antioxidant Armies: Dehydration inevitably generates reactive oxygen species (ROS)—highly reactive molecules like superoxide radicals (O₂⁻), hydrogen peroxide (H₂O₂), and hydroxyl radicals (OH·) that damage DNA, proteins, and lipids. While ROS serve as signaling molecules under normal conditions, their levels spike dramatically during drought.
Resurrection plants deploy a sophisticated antioxidant defense system. Enzymatic antioxidants include superoxide dismutase (SOD), which converts superoxide to hydrogen peroxide; catalase (CAT), which breaks hydrogen peroxide into water and oxygen; and ascorbate peroxidase (APX), which reduces hydrogen peroxide using ascorbate as an electron donor. Studies of Craterostigma plantagineum show SOD and CAT activity increases 3-5 fold during dehydration. Non-enzymatic antioxidants such as ascorbate (vitamin C), tocopherols (vitamin E), and tannins scavenge free radicals directly. Myrothamnus flabellifolius produces 3,4,5-tri-O-galloylquinic acid, a polyphenol that protects membranes against both desiccation and oxidative damage.
Recent research using near-infrared spectroscopy and aquaphotomics reveals an even more fundamental mechanism: resurrection plants restructure the water that remains. As Haberlea rhodopensis dries, free water molecules disappear and are replaced by water dimers and water with four hydrogen bonds—more stable molecular configurations that form a protective scaffold around proteins and membranes. This shift in water structure, not just water content, appears critical to survival. Upon rehydration, this structured water quickly reverts to normal states, triggering metabolic reactivation within hours.
The global food system faces a collision between rising demand and declining water availability. The UN projects world population will reach 9.7 billion by 2050, requiring 60% more food production. Yet agriculture already consumes 70% of global freshwater, and climate change is making droughts longer and more frequent. In 2024 alone, flash droughts—rapid-onset dry spells—devastated crops across the American Midwest, East Africa, and Central Asia.
Conventional crop breeding has largely exhausted gains in drought avoidance. We've bred plants with deeper roots, thicker cuticles, and more efficient stomata. But these strategies only delay dehydration; they don't enable survival once cellular water drops below critical thresholds. Resurrection plants offer a radically different approach: instead of avoiding drought, tolerate it completely.
Industry Transformation: Several industries stand to be revolutionized if resurrection plant mechanisms can be reliably engineered into crops. Seed companies like Bayer, Corteva, and Syngenta are racing to identify desiccation-tolerance genes that can be introduced via CRISPR without triggering GMO regulations. In 2024, researchers at the Innovative Genomics Institute used CRISPR to create transgene-free rice with enhanced water use efficiency by editing regulatory DNA adjacent to a photosynthetic gene, proving that targeted edits to native genes can improve drought response without introducing foreign DNA.
Vertical farming and controlled-environment agriculture could expand dramatically. Currently, these systems require constant irrigation because crop varieties lack any desiccation tolerance. Incorporating even partial resurrection traits could enable low-water production systems for leafy greens and vegetables, reducing urban agriculture's water footprint by 40-60%.
Smallholder farmers in sub-Saharan Africa and South Asia, who constitute 500 million households globally, would benefit most immediately. Many already grow orphan crops—like teff in Ethiopia—that are closely related to resurrection grasses. Eragrostis nindensis, a wild resurrection relative of teff, offers a genetic shortcut: comparing genomes may reveal which drought-tolerance genes were silenced during teff's domestication, allowing breeders to restore them through precise editing or conventional crossing.
Job Market Shifts: The agricultural biotechnology sector is projected to add 200,000+ jobs by 2030 as companies scale up drought-tolerance engineering. Roles in plant genomics, CRISPR editing, and field phenotyping are expanding rapidly. Universities are launching specialized programs in stress physiology and synthetic biology. At the same time, regions dependent on water-intensive crops like almonds (California) and rice (Southeast Asia) may see farm employment contract as production shifts to crops requiring less irrigation.
Cultural shifts are already underway. In Israel, a global leader in drip irrigation, farmers are partnering with biotech firms to test drought-tolerant wheat varieties that combine precision watering with enhanced desiccation recovery. The goal: maintain yields with 30% less water. In Australia, where rainfall variability has always challenged agriculture, resurrection plant research is a national priority, with government funding for genome sequencing of native desiccation-tolerant species like Tripogon loliiformis.
Resurrection plant biology opens extraordinary possibilities, but not without risks and challenges.
Solving Water Scarcity: If drought-tolerant crops become widespread, global water savings could exceed 500 billion cubic meters annually—equivalent to 200 million Olympic swimming pools. This water could be redirected to urban use, ecosystem restoration, or left in rivers to support biodiversity. Models suggest that drought-tolerant maize alone could prevent $15 billion in annual crop losses in the US.
Crops that survive flash droughts without permanent damage would stabilize food supplies. Currently, maize that experiences mid-season drought suffers 30-50% yield losses even if rain returns, because cellular damage is irreversible. Carlos Messina, a maize scientist at the University of Florida, notes that if engineered maize could recover like resurrection plants—fully restoring metabolic function after rehydration—productivity losses from short droughts would essentially disappear.
Beyond agriculture, resurrection plant mechanisms could revolutionize biopharmaceutical storage. Vaccines, insulin, and biologics currently require continuous refrigeration, making distribution in tropical regions expensive and unreliable. Companies are exploring trehalose coating and LEA protein formulations to stabilize these drugs in dry form at room temperature—a potential game-changer for global health equity.
Ecological Benefits: Resurrection plants play critical roles in arid ecosystems. Mosses like Syntrichia caninervis form biological soil crusts (biocrusts) across deserts, stabilizing soil, retaining moisture, and fixing atmospheric nitrogen. These crusts prevent erosion and create microhabitats for other organisms. Understanding their desiccation mechanisms could inform restoration of degraded drylands, which cover 40% of Earth's land surface and support 2 billion people.

Yet transforming crops into resurrection plants carries risks that demand serious consideration.
Yield Trade-offs: Desiccation tolerance isn't free. Producing massive amounts of trehalose, LEA proteins, and antioxidants requires energy and carbon that would otherwise go into seeds or fruits. Early transgenic studies showed that constitutive expression of desiccation-tolerance genes sometimes reduced yield by 10-20% under normal conditions. Farrant's team emphasizes the need for a "master switch" gene that activates protective mechanisms only during drought, avoiding the metabolic penalty during normal growth. Finding or engineering such precise control is a major challenge.
Genetic Complexity: Resurrection capability is not controlled by one or two genes—it's a coordinated network involving hundreds of genes, multiple metabolic pathways, and precise timing of expression. While single-gene insertions like XvAld1 in sweet potato have shown promise, full vegetative desiccation tolerance will likely require editing 10-20 loci simultaneously. Multiplex CRISPR technologies can theoretically achieve this, but predicting interactions among edits remains difficult. Off-target effects or unanticipated metabolic disruptions could compromise crop safety or performance.
Inequality and Access: Biotechnology advances often widen gaps between wealthy and poor farmers. If drought-tolerant seeds are protected by patents and priced beyond the reach of smallholders, the benefits will accrue to large-scale commercial farms in developed nations, leaving the world's most vulnerable farmers behind. Open-source breeding initiatives and compulsory licensing agreements will be essential to ensure equitable access.
Ecosystem Disruption: Crops that tolerate extreme drought might be grown in marginal lands currently unsuitable for agriculture, potentially displacing native ecosystems and reducing biodiversity. Additionally, if drought-tolerant crops escape cultivation, they could become invasive species in arid regions, outcompeting native resurrection plants and disrupting fragile desert ecologies. Policymakers will need robust biosafety frameworks to assess and mitigate these risks.
Attitudes toward engineering drought tolerance vary dramatically across regions, shaped by agricultural traditions, regulatory environments, and ethical frameworks.
In Europe, stringent GMO regulations have slowed adoption of transgenic crops, but gene-edited plants that lack foreign DNA face lighter scrutiny. The RESIST project exemplifies Europe's preference for understanding natural mechanisms first, then applying findings through biostimulants or precise editing rather than transgenics. European farmers and consumers prioritize sustainability and "naturalness," making molecular priming with algae extracts more culturally acceptable than genetic modification.
China, the world's largest agricultural producer, is aggressively pursuing both conventional breeding and CRISPR-based drought tolerance. Government research institutes have created drought-tolerant varieties of rice, wheat, and soy, viewing food security as a strategic imperative. Chinese scientists published the first CRISPR-edited drought-tolerant rice in 2021, and the regulatory pathway for gene-edited crops is streamlined compared to Europe or the US. China's top-down approach enables rapid deployment but raises concerns about inadequate public consultation.
In Africa, where 95% of agriculture is rainfed and droughts regularly cause famine, resurrection plants hold immense promise. South African researchers lead the field, with Professor Jill Farrant collaborating with universities across Kenya, Ethiopia, and Zimbabwe to identify native resurrection species and test crop engineering strategies. African governments are cautiously opening regulatory frameworks to gene editing, balancing hunger alleviation against concerns about foreign corporate control of seeds. The African Union's push for regional seed sovereignty aims to ensure African farmers can access and afford drought-tolerant varieties developed specifically for their crops and climates.
The United States maintains a patchwork regulatory system: gene-edited crops without foreign DNA are minimally regulated, while transgenic varieties face extensive review. American agribusiness has invested billions in drought tolerance, with Monsanto (now Bayer) launching DroughtGard maize in 2013—a transgenic variety that maintained yields during moderate drought. However, adoption has been slower than expected due to yield penalties under normal rainfall. The shift toward CRISPR-based editing of native genes offers a path to drought tolerance that avoids GMO labeling requirements, potentially accelerating farmer uptake.
India, home to 120 million small-scale farmers, has seen fierce public debate. While Bt cotton (insect-resistant, transgenic) is widely grown, attempts to introduce Bt brinjal (eggplant) sparked protests over food safety and biodiversity concerns. India's regulatory system remains cautious, but pilot projects testing drought-tolerant millet and sorghum—crops culturally important and closely related to resurrection grasses—may shift public opinion. Indian scientists have sequenced resurrection plants native to the Western Ghats, identifying candidate genes for tolerance to both drought and salinity, a dual threat in coastal regions.
As resurrection plant biology moves from lab to field, individuals and organizations can position themselves to participate in and benefit from this transition.
Skills to Develop: The biotech workforce will need specialists in CRISPR gene editing, plant phenotyping (measuring traits like water use efficiency and recovery speed), and bioinformatics to analyze massive genomic datasets from hundreds of resurrection species. Molecular biology training combined with data science skills will be in high demand. For farmers, understanding precision agriculture—using sensors to monitor soil moisture and plant stress in real time—will maximize the value of drought-tolerant varieties.
Agronomists and crop consultants should familiarize themselves with desiccation tolerance mechanisms to advise clients on variety selection and field trials. Extension services in drought-prone regions must prepare educational materials explaining how resurrection-inspired crops differ from conventional varieties in watering needs and stress management.
Institutional Adaptation: Seed companies must balance short-term profit motives with long-term food security. Licensing drought-tolerance genes at affordable rates to public breeding programs in developing countries will expand markets while serving humanitarian goals. Universities should establish cross-disciplinary programs linking plant biology, climate science, and agricultural economics to train the next generation of researchers.
Governments face a choice: invest in public-sector research to ensure drought tolerance remains accessible, or allow private companies to monopolize the technology through patents. Public funding for open-source gene editing projects, like the Open Source Seed Initiative, could democratize access.
Consumer Preparation: Public acceptance of gene-edited crops will shape their deployment speed. Educational campaigns highlighting the difference between transgenic GMOs (with foreign genes) and precision-edited crops (with only native genes modified) can build trust. Transparency about how drought-tolerant varieties are created and tested will be essential. Consumers can support resilient agriculture by choosing products from farmers who pilot sustainable water practices.
Investment and Policy: Venture capital is flowing into agri-biotech startups focused on stress tolerance, with over $2 billion invested globally in 2024. Investors should scrutinize companies for not just technological promise but also equitable access plans. Policymakers must update biosafety regulations to reflect the low risk of precision edits while requiring rigorous field testing for ecological impacts. International cooperation through organizations like the FAO and CGIAR can ensure that drought-tolerance research benefits the Global South, where climate impacts hit hardest.
Three hundred million years ago, plants cracked the code for surviving without water. That ancient innovation—refined in a tiny fraction of modern species scattered across deserts, rock faces, and windswept hillsides—is poised to transform how humanity feeds itself in an era of climate chaos. Resurrection plants don't merely endure drought; they embrace it, shutting down into suspended animation and awakening fully intact when water returns. This biological feat, once considered an evolutionary curiosity, is now recognized as a blueprint for the crops that will sustain 10 billion people on a hotter, drier planet.
The road ahead is neither simple nor certain. Engineering full vegetative desiccation tolerance into wheat or rice will require coordinating dozens of genes, navigating regulatory hurdles, and ensuring that benefits reach those who need them most. But incremental progress—crops that recover faster from drought, use water more efficiently, and maintain yields through short dry spells—is already within reach. Every percentage point improvement in drought resilience translates to millions of tons of grain saved and millions of people fed.
Perhaps the deepest lesson from resurrection plants is philosophical: survival sometimes requires letting go. These plants relinquish the ordinary metabolism that defines life, retreating into a state indistinguishable from death, trusting that the right conditions will return. In a world where climate uncertainty is the only certainty, that adaptive flexibility—encoded in sugars, proteins, and membranes refined over eons—may be the most valuable inheritance biology can offer us. The question is not whether we can learn from resurrection plants, but whether we can do so quickly enough and equitably enough to matter. The seeds of that answer are being planted right now, in labs and fields across the world, waiting for the right moment to come back to life.

Recent breakthroughs in fusion technology—including 351,000-gauss magnetic fields, AI-driven plasma diagnostics, and net energy gain at the National Ignition Facility—are transforming fusion propulsion from science fiction to engineering frontier. Scientists now have a realistic pathway to accelerate spacecraft to 10% of light speed, enabling a 43-year journey to Alpha Centauri. While challenges remain in miniaturization, neutron management, and sustained operation, the physics barriers have ...

Epigenetic clocks measure DNA methylation patterns to calculate biological age, which predicts disease risk up to 30 years before symptoms appear. Landmark studies show that accelerated epigenetic aging forecasts cardiovascular disease, diabetes, and neurodegeneration with remarkable accuracy. Lifestyle interventions—Mediterranean diet, structured exercise, quality sleep, stress management—can measurably reverse biological aging, reducing epigenetic age by 1-2 years within months. Commercial ...

Data centers consumed 415 terawatt-hours of electricity in 2024 and will nearly double that by 2030, driven by AI's insatiable energy appetite. Despite tech giants' renewable pledges, actual emissions are up to 662% higher than reported due to accounting loopholes. A digital pollution tax—similar to Europe's carbon border tariff—could finally force the industry to invest in efficiency technologies like liquid cooling, waste heat recovery, and time-matched renewable power, transforming volunta...

Humans are hardwired to see invisible agents—gods, ghosts, conspiracies—thanks to the Hyperactive Agency Detection Device (HADD), an evolutionary survival mechanism that favored false alarms over fatal misses. This cognitive bias, rooted in brain regions like the temporoparietal junction and medial prefrontal cortex, generates religious beliefs, animistic worldviews, and conspiracy theories across all cultures. Understanding HADD doesn't eliminate belief, but it helps us recognize when our pa...

The bombardier beetle has perfected a chemical defense system that human engineers are still trying to replicate: a two-chamber micro-combustion engine that mixes hydroquinone and hydrogen peroxide to create explosive 100°C sprays at up to 500 pulses per second, aimed with 270-degree precision. This tiny insect's biochemical marvel is inspiring revolutionary technologies in aerospace propulsion, pharmaceutical delivery, and fire suppression. By 2030, beetle-inspired systems could position sat...

The U.S. faces a catastrophic care worker shortage driven by poverty-level wages, overwhelming burnout, and systemic undervaluation. With 99% of nursing homes hiring and 9.7 million openings projected by 2034, the crisis threatens patient safety, family stability, and economic productivity. Evidence-based solutions—wage reforms, streamlined training, technology integration, and policy enforcement—exist and work, but require sustained political will and cultural recognition that caregiving is ...

Every major AI model was trained on copyrighted text scraped without permission, triggering billion-dollar lawsuits and forcing a reckoning between innovation and creator rights. The future depends on finding balance between transformative AI development and fair compensation for the people whose work fuels it.